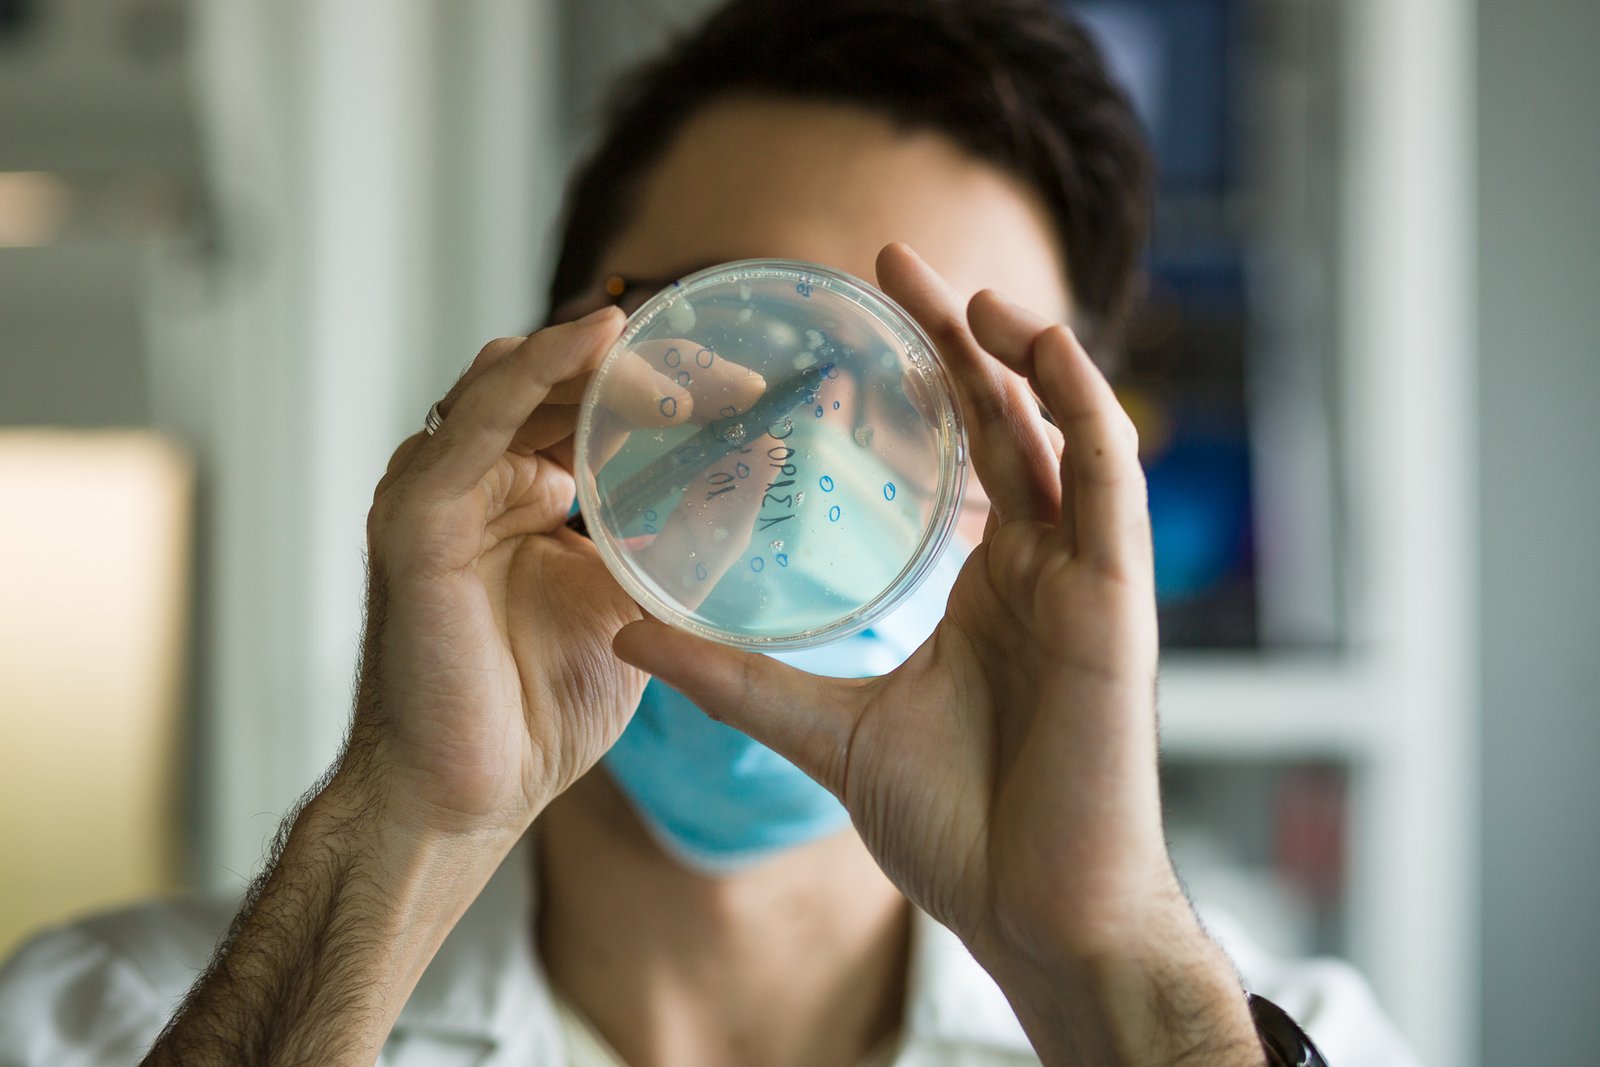

Corporativo
En la era digital y visual en la que vivimos, las imágenes juegan un papel crucial en la percepción que el público tiene de una organización. Cuando se trata de mejorar la imagen de marca, las fotografías permiten capturar la esencia de lo que la empresa representa. Cada imagen puede ser diseñada para transmitir emociones y reflejar la autenticidad y la filosofía de la marca.
Las fotografía corporativa establece una conexión emocional con el público objetivo. Transmite confianza, profesionalismo, innovación, sostenibilidad o cualquier otro valor clave que la empresa busque proyectar. La fotograía corporativa desempeña un papel crucial en la estrategia de branding de una empresa. Es una herramienta poderosa para comunicar los valores, la identidad y la historia de la marca.
A través de imágenes impactantes y auténticas, una empresa puede mejorar su imagen de marca, generar conexiones emocionales con su audiencia y destacar en un mercado cada vez más visual y competitivo.
¡Hablemos de tu proyecto!